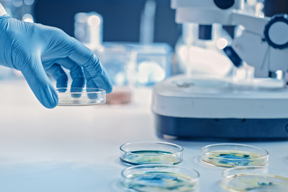
GettyImages-1212392754-petri-bacteria-plasmid-lab

MANUFACTURING

SF-RVN® Platform For Improving The Safety Profile Of Your Therapies
Discover how our Insect Cell Line provides a high performance platform optimal to produce recombinant proteins, viral vaccines, and adeno-associated vectors (AAV) for gene therapy applications.

Manufacturing Life-Saving Gene Therapies
Take a look behind the scenes and hear firsthand about the commitment to patients and clients at Andelyn Biosciences.

LC/MS Method For Measurement In Human Plasma
According to the researchers, this plasma-based measurement has the potential to serve as a critical pharmacodynamic biomarker, facilitating the assessment of novel therapeutic approaches.

A Transformative Journey From Research To Large-Scale Production
Learn about MilliporeSigma's journey to becoming a leader in clinical and commercial viral vector manufacturing and their support of cell and gene therapy innovators since the industry’s beginnings.

Mycap® CCX Cell Culture Expansion System
Grow cells in the incubator and passage between flasks without ever opening a flask and never going into a biosafety cabinet with MYCAP® CCX.

Freezing Studies For Single-Use Solutions: Long-Term (Part 2)
Watch part 2 of a four-part series, "Four Common Types Of Cryogenic Studies For Advanced Therapies," to learn about long-term freezing studies.

Challenges Of The IVT Reaction In mRNA Production
mRNA synthesizes from the plasma template in the in vitro transcription (IVT) step. Learn tips from a principal scientist for optimizing the IVT step of mRNA production and purification.

How Biologic Therapeutics Are Developed
Scientists are harnessing the power of cellular machinery to produce therapeutic biologics that can target specific conditions. Learn about the process of developing a biologic treatment.

MicroCNX Series Connectors Assembly Overview
In this video we demonstrate how easy it is to use MicroCNX connectors. A quick and easy three step process results in a secure, leak-free connection.

How To Maintain A Nuclease Free Environment During mRNA Production
mRNA are singled-stranded, and their chemistry makes them more susceptible to enzyme degradation than double-stranded DNA. Learn how to maintain a nuclease free environment during mRNA production and purification.

How MilliporeSigma Promotes Quality And Risk Reduction
Learn how MilliporeSigma’s new facility was built with quality and risk reduction at the top of mind and its experts have the experience to support large-scale programs through commercialization.

Supporting Biopharma Manufacturing With Freezing Study Capabilities
Learn about an Innovation Hub that specializes in freezing studies to provide insight into the performance of single-use cryopreservation solutions for manufacturing and delivering advanced therapies.

Assuring Viral Safety: Better, Faster, Virus Production
Viral safety is tricky when your product is a virus. Learn about the strategies that can help prevent, detect and remove the “bad” viruses from your virus production processes.

Compare How Two Types Of Technology Measure AAV Viral Titer
Compare the difference between ddPCR™ technology and plate-based digital PCR technologies.

Connect And Disconnect Aseptically Using Sterile Connection Technology
In this video, we review how assembling is a quick and easy three-step process - flip, click, and pull. See how to follow these steps to ensure a secure, leak-free connection.

Harvesting In The PBS Mini
Learn efficient ways to harvest cells after a run, including pipette and bottom-port aspiration techniques.

Understanding Our Single-Use Mixing System
Watch how our single-use mixing system creates a completely sterile mixing and recirculation process, ensuring your buffer and media are mixed correctly and efficiently.

Batching In The PBS Mini
Learn how to properly batch your cell culture vessel, equilibrating media to create a stable and consistent environment for optimal cell growth.
Detecting Mycoplasma Contamination In Your Cell Culture
Learn about Droplet Digital PCR, the mycoplasma detection kit workflow, how it can provide higher sensitivity, quantitative readout reports and more.

DNA Sizing Data & Quantifying Residual HEK293 Host Cell DNA
Learn about key considerations for measuring HEK293 DNA in your cell and gene therapy products and how you can perform residual DNA sizing and quantification with a single instrument.

Simplify Your Downstream Calculations With Bioprocessing Downstream Calculators
Simplify complex biopharma downstream processing tasks using a suite of powerful, web-based calculators designed to streamline workflows and automate intricate mathematical modeling.

Mycap® Bottle Closures – Aseptic Fluid Transfer Systems For Bottles
The innovative MYCAP bottle closure system provides more options for aseptic fluid transfer in bottles and rigid containers. The elastomeric closure makes it a truly universal closure system.
Freezing Studies For Single-Use Solutions
Learn about the four common types of cryogenic studies for advanced therapies: controlled-rate, long-term, therapy containment/protection, and transportation.

Single-Use Filter Transfer Sets Ready For Final Filling
Our industry-first, preconfigured filter transfer set for final filling arrives up to 80% faster, is PUPSIT-optimized, sterile and ready to use.

Meet The PBS Mini Vertical-Wheel Bioreactor
Discover a scaled-down bioreactor offering superior, gentle mixing in 60-100mL and 300-500mL working volumes. Learn about its key features and universal base.

3rd Generation Filling System Video
3rd Generation Filling System is an automated bag filling platform for GMP manufacturing.

Combining Expertise With Best-In-Class Technology
Members of the MilliporeSigma leadership team reflect on the longstanding experience of our BioReliance® viral vector manufacturing facilities. Our legacy experience, alongside our brand new facility and latest industry innovations, ensure we are a preferred partner t...

Cell And Gene Therapy Formulation And Fill Platform
Solving commercial manufacturing challenges in cell and gene therapy.

Microcarrier Separation Systems
Ross Acucena, applications director, and Donnie Beers, product manager, introduce our highly functional and adaptable microcarrier cell separation bags designed for single-use processes.

AsepitQuik S Steam-Thru II Combination Connector
Product Manager Maria Bollensen introduces the newest addition to the AseptiQuik® product line of sterile connectors, AseptiQuik STC Connectors integrate the AseptiQuik sterile connector and the Steam-Thru II SIP connector, giving manufacturers greater flexibility bet...
